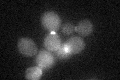
YPL158C
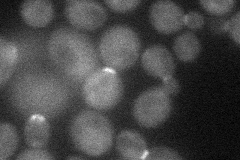
YPL158C
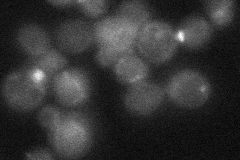
YPL158C

View description
Protein of unknown function; GFP-fusion protein localizes to the bud neck; transcription is regulated by Swi5p; null mutant displays elevated frequency of mitochondrial genome loss
Localization:
Intensity:
Fold change:
Significance:
-
C’ GFP library in SD
bud neckN/A -
N' NOP1pr-GFP in SD
bud neck28.7841 -
N' TEF2pr-mCherry in SD

nucleus5.84963 -
N' NATIVEpr-GFP in SD
bud neck19.1268 -
N' TEF2pr-VC and Cyto-VN in SD

#N/A0 -
C’ GFP library in SD+DTT

bud neck20.540.94No -
C’ GFP library in SD+H2O2

bud neck19.360.88No -
C’ GFP library in Starvation Media

cytosol16.70.76No -
C’ GFP library on the background of Pup2-DaMP

bud neck -
C’ GFP library on the background of CCT mutant

bud neck21.34980.978725No
